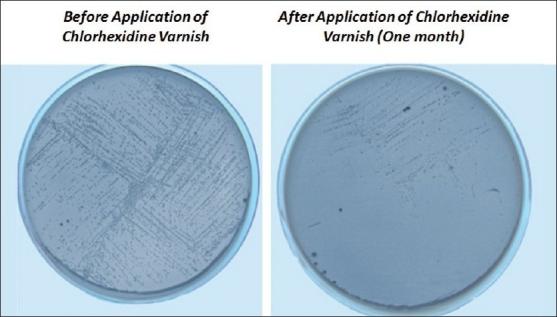
https://cdn.ncbi.nlm.nih.gov/pmc/blobs/ea7a/3100861/8efc39e1981f/JISP-14-178-g001.jpg

洗必泰清漆可有效抑制牙龈卟啉单胞菌和变形链球菌——一项体内研究。
Chlorhexidine varnishes effectively inhibit Porphyromonas gingivalis and Streptococcus mutans - an in vivo study.
作者信息
George Ashwin Mathew, Kalangi Suresh Kumar, Vasudevan Mithuna, Krishnaswamy N R
机构信息
Department of Orthodontics, Ragas Dental College, Chennai, Tamil Nadu, India.
出版信息
J Indian Soc Periodontol. 2010 Jul;14(3):178-80. doi: 10.4103/0972-124X.75913.
BACKGROUND
Chlorhexidine varnish (Cervitec- Ivoclar Vivadent- Liechtenstein) is a sustained-release delivery system that can provide protection against white spots and gingivitis, which are common iatrogenic side effects of orthodontic treatment. Chlorhexidine in varnish form does not depend on patient compliance, does not stain teeth or alter taste sensation like the mouth rinse.
MATERIALS AND METHODS
A split-mouth technique was followed in the treatment of 30 patients selected by stringent selection criteria, evaluating a single application of the test varnish on two randomly allotted quadrants along with a placebo on the other two quadrants. Streptococcus mutans counts responsible for white spots and P. gingivalis count [using PCR test] responsible for gingivitis were done at the start of the study, and then 1 and 3 months later.
RESULTS
The chlorhexidine varnish reduced the Streptococci mutans count at the end of 1 month, and this reduction was statistically significant. At the end of 3 months, there was no difference in the S. mutans counts between the two groups. There was a statistically significant reduction in the P. gingivalis count at the end of both 1 and 3 months in comparison to the placebo group.
CONCLUSION
Chlorhexidine varnishes are capable of reducing S. mutans and P. gingivalis and gingivitis, thus improving the overall oral health of the patient. The side effects of chlorhexidine mouth rinses are not seen with this varnish. An application schedule of at least once a month is recommended as the effectiveness is reduced comparatively at the end of 3 months.
背景
洗必泰清漆(Cervitec - 义获嘉伟瓦登特公司 - 列支敦士登)是一种缓释给药系统,可预防正畸治疗常见的医源性副作用——白斑和牙龈炎。清漆形式的洗必泰不依赖患者的依从性,不会像漱口水那样使牙齿染色或改变味觉。
材料与方法
对30名经严格筛选标准选出的患者采用双侧对照技术进行治疗,在随机分配的两个象限中评估单次应用试验清漆,另外两个象限应用安慰剂。在研究开始时、1个月后和3个月后分别检测导致白斑的变形链球菌计数以及[使用聚合酶链反应检测]导致牙龈炎的牙龈卟啉单胞菌计数。
结果
1个月末,洗必泰清漆使变形链球菌计数降低,且这种降低具有统计学意义。3个月末,两组间变形链球菌计数无差异。与安慰剂组相比,1个月末和3个月末牙龈卟啉单胞菌计数均有统计学意义的降低。
结论
洗必泰清漆能够降低变形链球菌和牙龈卟啉单胞菌数量以及牙龈炎发生率,从而改善患者的整体口腔健康状况。这种清漆不会出现洗必泰漱口水的副作用。建议至少每月应用一次,因为在3个月末其效果相对降低。